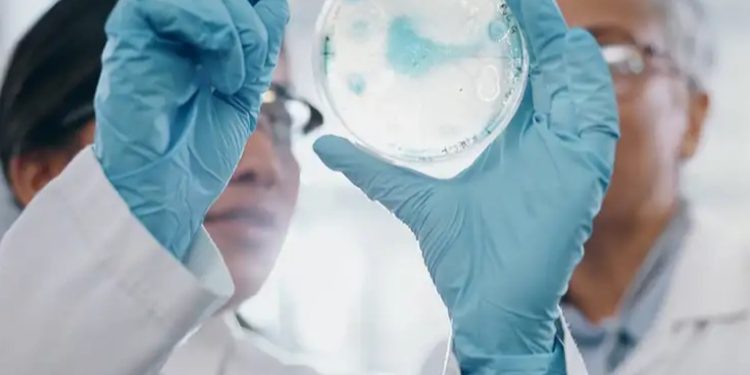
Cazadores de virus rastrean amenazas para evitar pandemia

2024-09-26
Nuevo Mundo – 96.1
Una red global de doctores y laboratorios opera desde 2021 para detectar la aparición de nuevas amenazas virales, muchas motivadas por el cambio climático, en un intento de evitar la próxima pandemia mundial.Esta coalición de «cazadores de virus», como se llaman a ellos mismos, ha destapado ya una inusual enfermedad transmitida por garrapatas en Tailandia o un brote infeccioso en Colombia propagada por mosquitos.»La relación de cuestiones por las que nos tenemos que preocupar, como vimos en el COVID-19, no es estática», afirma Gavin Cloherty, experto en enfermedades infecciosas que dirige la Coalición de Defensa contra Pandemias de Abbott.»Tenemos que estar muy atentos a los tipos malos que ya conocemos y que están evolucionando (…) Pero también a si hay nuevos niños en el barrio», dice a la AFP.La importancia de anticiparLa coalición reúne a doctores y científicos en universidades e instituciones sanitarias de todo el mundo, financiados por el gigante de dispositivos médicos y sanitarios Abbott.Al descubrir nuevas amenazas, la coalición otorga a la empresa una ventaja a la hora de diseñar los test diagnósticos que fueron claves en la respuesta a la pandemia del COVID. Su implicación dota a la coalición de amplios recursos y de la capacidad de detectar y secuenciar, pero también responder a los nuevos virus.»Cuando encontramos algo, somos capaces de desarrollar rápidamente test de diagnóstico a nivel industrial», dice Cloherty. «La idea es contener un brote, de forma que podamos prevenir una pandemia», agrega.La coalición ha secuenciado aproximadamente 13.000 muestras desde que empezó a funcionar en 2021.En Colombia descubrió un brote de Oropouche, un virus transmitido por jejenes y mosquitos que apenas se había observado previamente. El trabajo filogenético para trazar el árbol familiar de la cepa reveló que procedía de Perú o Ecuador y no de Brasil, otro foco de esta enfermedad.Más recientemente, la coalición trabajó con médicos en Tailandia para descubrir que un virus propagado por garrapatas estaba detrás de un misterioso grupo de casos de pacientes enfermos.»Puedes ver de dónde vienen las cosas. Es importante desde una perspectiva de salud pública», afirma Cloherty. «Tenemos que estar atentos», afirma. «Algo que pasa ahora en Bangkok puede estar ocurriendo mañana en Boston».
Una red global de doctores y laboratorios opera desde 2021 para detectar la aparición de nuevas amenazas virales, muchas motivadas por el cambio climático, en un intento de evitar la próxima pandemia mundial.
Esta coalición de «cazadores de virus», como se llaman a ellos mismos, ha destapado ya una inusual enfermedad transmitida por garrapatas en Tailandia o un brote infeccioso en Colombia propagada por mosquitos.
«La relación de cuestiones por las que nos tenemos que preocupar, como vimos en el COVID-19, no es estática», afirma Gavin Cloherty, experto en enfermedades infecciosas que dirige la Coalición de Defensa contra Pandemias de Abbott.
«Tenemos que estar muy atentos a los tipos malos que ya conocemos y que están evolucionando (…) Pero también a si hay nuevos niños en el barrio», dice a la AFP.
La coalición reúne a doctores y científicos en universidades e instituciones sanitarias de todo el mundo, financiados por el gigante de dispositivos médicos y sanitarios Abbott.
Al descubrir nuevas amenazas, la coalición otorga a la empresa una ventaja a la hora de diseñar los test diagnósticos que fueron claves en la respuesta a la pandemia del COVID. Su implicación dota a la coalición de amplios recursos y de la capacidad de detectar y secuenciar, pero también responder a los nuevos virus.
«Cuando encontramos algo, somos capaces de desarrollar rápidamente test de diagnóstico a nivel industrial», dice Cloherty. «La idea es contener un brote, de forma que podamos prevenir una pandemia», agrega.
La coalición ha secuenciado aproximadamente 13.000 muestras desde que empezó a funcionar en 2021.
En Colombia descubrió un brote de Oropouche, un virus transmitido por jejenes y mosquitos que apenas se había observado previamente. El trabajo filogenético para trazar el árbol familiar de la cepa reveló que procedía de Perú o Ecuador y no de Brasil, otro foco de esta enfermedad.
Más recientemente, la coalición trabajó con médicos en Tailandia para descubrir que un virus propagado por garrapatas estaba detrás de un misterioso grupo de casos de pacientes enfermos.
«Puedes ver de dónde vienen las cosas. Es importante desde una perspectiva de salud pública», afirma Cloherty. «Tenemos que estar atentos», afirma. «Algo que pasa ahora en Bangkok puede estar ocurriendo mañana en Boston».